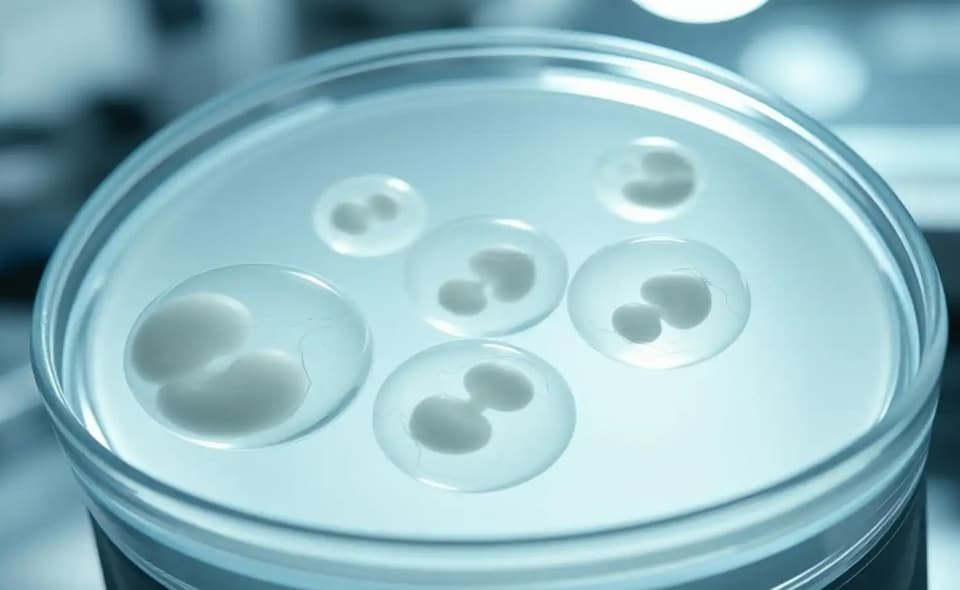

วงการวิทยาศาสตร์การแพทย์สั่นสะเทือน หลังนักวิทยาศาสตร์จากสหรัฐอเมริกาประสบความสำเร็จในการสร้าง “ตัวอ่อนมนุษย์ระยะเริ่มต้น” จาก DNA ที่สกัดจากเซลล์ผิวหนัง เป็นครั้งแรกของโลก ความก้าวหน้านี้อาจปูทางสู่การรักษาภาวะมีบุตรยาก และเปลี่ยนวิธีคิดเกี่ยวกับการสืบพันธุ์มนุษย์ในอนาคต
ก้าวกระโดดทางวิทยาศาสตร์
ทีมนักวิจัยจากมหาวิทยาลัยสุขภาพและวิทยาศาสตร์แห่งรัฐออริกอน ใช้เทคนิคดัดแปลงเซลล์ผิวหนัง โดยนำ “นิวเคลียส” ซึ่งเป็นที่เก็บรหัสพันธุกรรมทั้งหมด ใส่เข้าไปในไข่ของผู้บริจาคที่ถูกนำคำสั่งทางพันธุกรรมออกแล้ว วิธีนี้คล้ายกับการสร้าง “แกะดอลลี” สัตว์โคลนนิ่งตัวแรกของโลกเมื่อปี 2539
เพื่อให้ไข่สามารถผสมกับอสุจิได้ นักวิจัยต้องทำให้มันลดจำนวนโครโมโซมจาก 46 ชุดเหลือ 23 ชุด ผ่านกระบวนการที่เรียกว่า ไมโตไมโอซิส (mitomeiosis) ก่อนจะทำการปฏิสนธิ ผลการทดลองพบว่าสามารถสร้างไข่ใช้งานได้ 82 ฟอง และบางฟองพัฒนาไปสู่ “ตัวอ่อนระยะเริ่มต้น” ได้สำเร็จ แม้จะยังไม่สามารถพัฒนาเกิน “6 วัน”
ความหมายและความท้าทาย

ความก้าวหน้านี้เปิดโอกาสใหม่ต่อการรักษาภาวะมีบุตรยาก โดยเฉพาะผู้ที่อายุมาก คู่รักเพศเดียวกัน หรือผู้ที่มีโรคทางพันธุกรรม อย่างไรก็ตาม อัตราความสำเร็จยังต่ำมากเพียง 9% และยังพบความผิดพลาดในการจัดเรียงโครโมโซม เช่น บางชนิดถูกทำซ้ำ ในขณะที่บางชนิดหายไป
ศาสตราจารย์ ชุคห์รัท มิตาลิปอฟ หัวหน้าทีมวิจัย กล่าวอย่างมั่นใจว่า “เราบรรลุสิ่งที่ครั้งหนึ่งเคยคิดว่าเป็นไปไม่ได้” พร้อมย้ำว่ายังต้องปรับปรุงเทคนิคให้สมบูรณ์แบบ เพื่อหลีกเลี่ยงความผิดปกติทางพันธุกรรมในอนาคต
แม้การนำวิธีนี้มาใช้จริงในคลินิกรักษาภาวะมีบุตรยากอาจต้องใช้เวลาอีกนับสิบปี แต่งานวิจัยครั้งนี้ถือเป็นก้าวสำคัญที่เปลี่ยนกฎเกณฑ์การกำเนิดชีวิต และเปิดบทสนทนาครั้งใหม่เกี่ยวกับจริยธรรมและวิทยาศาสตร์การแพทย์ที่อาจเปลี่ยนโฉมโลกได้ในอนาคต
tags : BBC
















